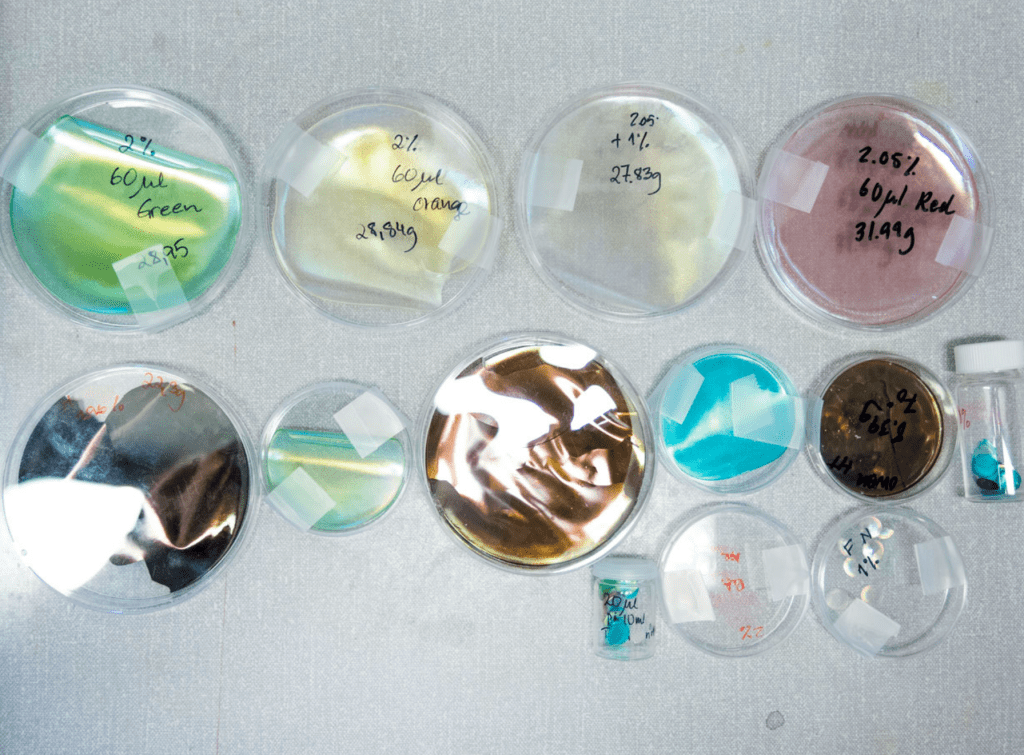

Author and Maker
Designer 1
I’m starting my research with one of my favourite biological designers Ross Lovegrove who is inspired by forms in nature. Lovegrove describes his work as a combination of technology, materials science and intelligent organic form. However, as I have used his work for research before I want to look at other designers in the field of bio design, therefore I’m looking at Dezeen’s synthetic biology category.
Elissa Brunato
Concept Designer / Sustainable Material Explorer / Design Researcher
Bio Iridescent Sequin
Brunato’s work is targeting a specific area of the market where there are gaps in sustainable practise – the fashion industry. This is also a collaborative project, with Elissa working alongside Material Scientists from RISE research institute (Hjalmar Granberg and Tiffany Abitbol). I would say this is a passion project as all three collaborators are striving to generate safer and more environmentally sustainable materials, particularly as fast-fashion is a huge contributor to environmental pollution (the V&A London did a great exhibition highlighting these issues here)
These sequins are a winner of the Green trail, Maison/0 Prize and the Mills Fabrica Material Innovation Prize. 2019 MullenLowe NOVA Award Runners Up and Winner of 2019 Creative Review Innovation Award.
Designer 2 –
Neri Oxman
Multi-Disciplinary Designer / Architect / Scientist / Inventor
Oxman has released a number of Ted talks which is how I first discovered her – this video being one:
Aguahoja
The material is capable of being developed with alternative thickness, strength and transparencies and therefore can be manipulated into various uses e.g. sculptures, bags and windows.
I would describe Oxman’s work as a passion project and very much like Elissa Brunato, showcasing ecological products that have a valid place in the market. Oxman’s work involves generating scientific material and combines technology in nearly all of her projects, therefore I wouldn’t say this is her sole output. For the particular project above, there was a hefty amount of people involved in the “research team” and this is often the case with her projects.
Summary
The market both designers are targeting – new technologies and scientific material systems – is competitive with the evolution of sustainability trends and advances in technology on the rise. However despite this I feel that their work is so thoroughly developed, researched and presented (alongside having won awards) that they are unique.
They also are both collaborative projects which is interesting – I feel that this is down to a couple of things: one being that as the work involves so many processes and experiments in different fields of practise collaboration is inevitable, and two, having colleagues with experience, history and knowledge on projects strengthens the ideas.
The differences between both is that one has less research involved with less people (Brunato), and one is heavily research based (Oxman). Arguably the scale is what makes that a requirement – the heavily research based project was producing outcomes of a much larger, stronger scale. I would be interested to know what the impact of having less researchers would have been on the final outcome – would 20 members have been necessary?